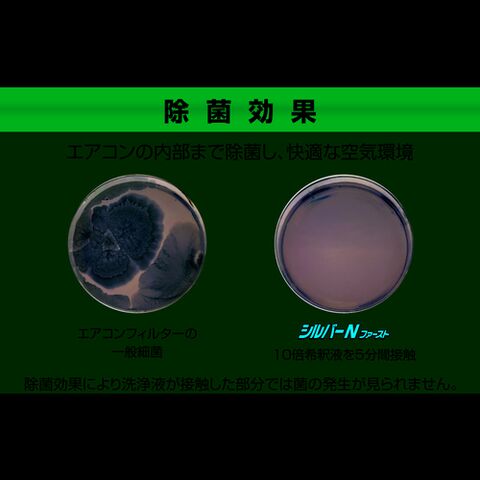

5/23
時点_ポイント最大15倍
横浜油脂工業 アルミフィンクリーナー シルバーNファースト 20kg LINDA NB51 【返品種別B】
販売価格
12,200
円 (税込)
送料無料
- 出荷目安:
- お取り寄せ/補足(目安):取引先在庫あり3日~5日で出荷
たまるdポイント(通常) 110
+キャンペーンポイント(期間・用途限定) 最大14倍
※たまるdポイントはポイント支払を除く商品代金(税抜)の1%です。
※表示倍率は各キャンペーンの適用条件を全て満たした場合の最大倍率です。
各キャンペーンの適用状況によっては、ポイントの進呈数・付与倍率が最大倍率より少なくなる場合がございます。
dカードでお支払ならポイント3倍
各キャンペーンの適用状況によっては、ポイントの進呈数・付与倍率が最大倍率より少なくなる場合がございます。
- 商品情報
- レビュー
【重要】お買い物前に必ずこちらをお読み下さい(外部リンク)
□「返品種別」について詳しくはこちら(外部リンク)□
□メーカーページへ(外部リンク)
□「返品種別」について詳しくはこちら(外部リンク)□
□メーカーページへ(外部リンク)
◆強力な洗浄力と除菌効果でエアコンアルミフィンのメンテナンスに最適です。
◆エアフィルタや熱交換器を洗浄することで、消費電力を削減できCO2排出量を削減します。
◆アルミフィン・フィルター・空気清浄機の集塵板の油汚れ、ヤニ等の洗浄に。
■ 仕 様 ■
- 容量:16.39L
- 色:黄色透明
- 物質状態:アルカリ性
- 希釈倍率:10~50倍
- 縦:340mm
- 横:180mm
- 強力タイプ
- 成分:水酸化ナトリウム、水酸化カリウム、キレート剤、陰イオン界面活性剤、消臭剤、銀イオン